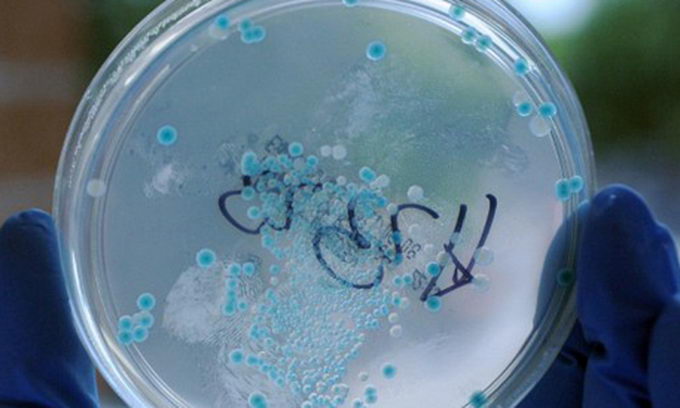

Небезпечна кишкова інфекція дісталася до Польщі
Санітарна інспекція Польщі підтвердила, що в країні зафіксовано перший випадок зараження штамом бактерії E.сoli. Бактерію виявлено у 29-річної жінки, яка кілька днів тому приїхала з Німеччини, де вона постійно проживає.
Санітарна інспекція Польщі підтвердила, що в країні зафіксовано перший випадок зараження штамом бактерії E.сoli. Бактерія була виявлена в 29-літньої жінки кілька днів тому, однак тільки в понеділок інформація підтвердилася. Жінка, що постійно проживає в Німеччині, потрапила в лікарню 23 травня у Великопольскому воєводстві, зараз вона перебуває на лікуванні в місті Щецин.
Ще двоє чоловіків знаходяться у цій же лікарні з підозрами на наявність цієї бактерії, пише «Сегодня».
Як відомо, кишкова інфекція в Європі була зафіксована на півночі Німеччини. За даними Всесвітньої організації охорони здоров’я (ВООЗ), випадки захворювання зареєстровані вже в десяти країнах Європи. Повідомлялося також про смерть одного пацієнта у Швеції. Росспоживнагляд РФ увів обмеження на ввіз із усіх країн ЄС овочів — імовірних джерел інфекції.
Нагадаємо, 6 червня влада Німеччини заявила, що спалах кишкової інфекції в Європі могли викликати пагони бобових з місцевих теплиць.
Раніше повідомлялося, що Україна посилить контроль на кордоні на ввезення овочів з Європейського Союзу. Росія ж заборонила імпорт на овочеву продукцію з Європи.
31 травня міністр охорони здоров'я в уряді Гамбурга Корнелія Прюфер-Штрокс заявила, що іспанські огірки не є джерелом гострої кишкової інфекції, від якої у Німеччині вже померли 14 людей.
В Україні інфекції поки виявлено не було. 2 червня Прем'єр-міністр України Микола Азаров заявив, що Україна посилила контроль на кордоні за ввезенням овочів з країн Європейського Союзу.
Зараз за сприяння ВООЗ проводиться інтенсивне розслідування з метою встановлення джерела спалаху, яке досі не визначено.
ВООЗ, у відповідності до вимог Міжнародних медико-санітарних правил, безперервно інформує держави-члени про останні події та надає технічні рекомендації з подальшого розслідування спалаху небезпечного захворювання.
Раніше повідомлялося, що різновид кишкової палички, що викликала спалах захворювання в Західній Європі, є новим, раніше невідомим науці штамом.






